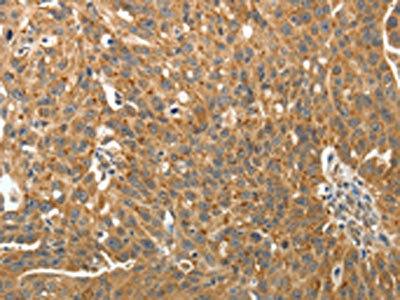

RARA Antibody
-
中文名稱:RARA兔多克隆抗體
-
貨號:CSB-PA916321
-
規格:¥1100
-
圖片:
-
The image on the left is immunohistochemistry of paraffin-embedded Human ovarian cancer tissue using CSB-PA916321(RARA Antibody) at dilution 1/40, on the right is treated with fusion protein. (Original magnification: ×200)
-
The image on the left is immunohistochemistry of paraffin-embedded Human liver cancer tissue using CSB-PA916321(RARA Antibody) at dilution 1/40, on the right is treated with fusion protein. (Original magnification: ×200)
-
Gel: 10%SDS-PAGE, Lysate: 40 μg, Lane: Human fetal lung tissue, Primary antibody: CSB-PA916321(RARA Antibody) at dilution 1/700, Secondary antibody: Goat anti rabbit IgG at 1/8000 dilution, Exposure time: 1 minute
-
-
其他:
產品詳情
-
Uniprot No.:
-
基因名:
-
別名:NR1B1 antibody; Nuclear mitotic apparatus protein retinoic acid receptor alpha fusion protein antibody; Nuclear receptor subfamily 1 group B member 1 antibody; Nucleophosmin retinoic acid receptor alpha fusion protein NPM RAR long form antibody; RAR alpha antibody; RAR antibody; RAR-alpha antibody; rara antibody; RARA_HUMAN antibody; RARalpha antibody; RARalpha1 antibody; Retinoic acid nuclear receptor alpha variant 1 antibody; Retinoic acid nuclear receptor alpha variant 2 antibody; Retinoic acid receptor alpha antibody; Retinoic acid receptor alpha polypeptide antibody
-
宿主:Rabbit
-
反應種屬:Human,Mouse
-
免疫原:Fusion protein of Human RARA
-
免疫原種屬:Homo sapiens (Human)
-
標記方式:Non-conjugated
-
抗體亞型:IgG
-
純化方式:Antigen affinity purification
-
濃度:It differs from different batches. Please contact us to confirm it.
-
保存緩沖液:-20°C, pH7.4 PBS, 0.05% NaN3, 40% Glycerol
-
產品提供形式:Liquid
-
應用范圍:ELISA,WB,IHC
-
推薦稀釋比:
Application Recommended Dilution ELISA 1:2000-1:5000 WB 1:500-1:2000 IHC 1:50-1:200 -
Protocols:
-
儲存條件:Upon receipt, store at -20°C or -80°C. Avoid repeated freeze.
-
貨期:Basically, we can dispatch the products out in 1-3 working days after receiving your orders. Delivery time maybe differs from different purchasing way or location, please kindly consult your local distributors for specific delivery time.
-
用途:For Research Use Only. Not for use in diagnostic or therapeutic procedures.
相關產品
靶點詳情
-
功能:Receptor for retinoic acid. Retinoic acid receptors bind as heterodimers to their target response elements in response to their ligands, all-trans or 9-cis retinoic acid, and regulate gene expression in various biological processes. The RXR/RAR heterodimers bind to the retinoic acid response elements (RARE) composed of tandem 5'-AGGTCA-3' sites known as DR1-DR5. In the absence of ligand, the RXR-RAR heterodimers associate with a multiprotein complex containing transcription corepressors that induce histone deacetylation, chromatin condensation and transcriptional suppression. On ligand binding, the corepressors dissociate from the receptors and associate with the coactivators leading to transcriptional activation. Formation of a complex with histone deacetylases might lead to inhibition of RARE DNA element binding and to transcriptional repression. Transcriptional activation and RARE DNA element binding might be supported by the transcription factor KLF2. RARA plays an essential role in the regulation of retinoic acid-induced germ cell development during spermatogenesis. Has a role in the survival of early spermatocytes at the beginning prophase of meiosis. In Sertoli cells, may promote the survival and development of early meiotic prophase spermatocytes. In concert with RARG, required for skeletal growth, matrix homeostasis and growth plate function. Together with RXRA, positively regulates microRNA-10a expression, thereby inhibiting the GATA6/VCAM1 signaling response to pulsatile shear stress in vascular endothelial cells. In association with HDAC3, HDAC5 and HDAC7 corepressors, plays a role in the repression of microRNA-10a and thereby promotes the inflammatory response.
-
基因功能參考文獻:
- Semiquantitative and quantitative analyses of the markers RARA and CRABP2 indicate their potential as biomarkers for tumor progression and their participation in nephroblastoma tumorigenesis PMID: 29378601
- The level of RARalpha gene expression as a potential prognostic factor in the pathogenesis of multiple myeloma. PMID: 29119395
- The data demonstrate that RARalpha drives integrin beta7-dependent adhesion and CCR9-mediated chemotaxis in CTCL cells. PMID: 28370539
- Silencing of PML-RAR and RARalpha2 results in similar increases in the constitutive expression of several granulocytic differentiation markers. PMID: 27419624
- RARA drives cyclin-dependent kinase expression, G1-S transition, and cell growth in T-cell lymphoma. PMID: 28412739
- Demonstrate that RARalpha was frequently elevated in gastric carcinoma and exerted oncogenic properties via positive feedback loop of IL-1beta/Akt/RARalpha/Akt signaling. PMID: 28035062
- Our findings unveil a novel essential oncogenic activity of PML/RARA in Acute promyelocitic leukemia PMID: 27626703
- Findings reveal a previously unrecognized role of c-Myc as a potential ceRNA for PML/RARalpha in acute promyelocytic leukemia. PMID: 27486764
- RARalpha regulates Arp2/3-mediated actin cytoskeletal dynamics through a non-genomic signaling pathway PMID: 26848712
- It has been shown that the AP-1 family member JunB and retinoic acid receptor alpha (RARa) mediate catalase transcriptional activation and repression, respectively, by controlling chromatin remodeling through a histone deacetylases-dependent mechanism. PMID: 27591797
- Work identifies the TP53 tumor suppressor as a novel target through which NPM1-RARA impacts leukemogenesis. PMID: 26754533
- Dual small interfering RNA (siRNA) silencing of RARalpha and RARgamma reversed RA blockade of P4-induced CK5. Using promoter deletion analysis, we identified a region 1.1 kb upstream of the CK5 transcriptional start site that is necessary for P4 activation and contains a putative progesterone response element (PRE PMID: 28692043
- High RARA expression is associated with acute myeloid leukemia. PMID: 28416638
- Data suggest that the binding of Z-10 to RXRalpha inhibited the interaction of RXRalpha with PML-RARalpha, leading to Z-10's selective induction of PML-RARalpha degradation. PMID: 28129653
- PML-RARa bcr1 fusion is not responsible for colorectal tumor development. PMID: 22167334
- overexpression of NLS-RARalpha promoted the proliferation of APL cells and inhibited their differentiation via the PI3K/AKT signaling pathway. PMID: 27840989
- r study demonstrated that ATRA cound promote differentiation while inhibit proliferation of acute promyelocytic leukemia NB4 cells via activating p38a protein after recruiting p38a-combinded NLS-RARa, while NLS-RARa could inhibit the effects of ATRA in the process. PMID: 27499693
- Low expression of RARalpha was independently associated with worse progression-free survival following platinum-based chemotherapy of advanced Non-small cell lung cancer. PMID: 27306217
- The classical counterpart of RARalpha, retinoid X receptor alpha (RXRalpha), was down-regulated in both cytoplasm and nucleus of A549 cells upon atRA addition. PMID: 26818829
- RAI1 polymorphisms rs4925102 and rs9907986 are predicted to disrupt the binding of retinoic acid RXR-RAR receptors and the transcription factor DEAF1, respectively, in Smith-Magenis and Potocki-Lupski syndromes patients. PMID: 26743651
- Data suggest that hematopoietically expressed homeobox protein (HHEX) downmodulation by promyelocytic leukemia-retinoic acid receptor alpha fusion oncoprotein (PML-RARalpha) is a key event during acute promyelocytic leukemia (APL) pathogenesis. PMID: 27052408
- ATRA dramatically down regulated RARalpha protein levels and led to more DNA damage and ultimately resulted in the synergism of these two agents PMID: 26728137
- NPM-RAR binding to TRADD selectively inhibits caspase activation, while allowing activation of NFkappaB and JNK PMID: 25791120
- Suggest a novel role of PCGF2 in arsenic trioxide-mediated degradation of PML-RARA that PCGF2 might act as a negative regulator of UBE2I via direct interaction. PMID: 27030546
- down-regulation of the level of RAR alpha leads to increased expression of VDR in acute myeloid leukemia. PMID: 26969398
- Methylated arsenic metabolites bind to PML protein but do not induce cellular differentiation and PML-RARalpha protein degradation in acute promyelocytic leukemia. PMID: 26213848
- Novel insight into the functional difference of acquired mutations of PML-RARA both in vitro and in the clinical setting. PMID: 26537301
- our findings challenge the predominant model in the field and we propose that PML/RARA initiates leukemia by subtly shifting cell fate decisions within the promyelocyte compartment. PMID: 26088929
- RARalpha might be involved in the pathogenesis of varicocele as its expression is reduced in pathologic samples. PMID: 24992177
- The PML-region mutations were associated with response to Arsenic trioxide-based therapy (P < 0.0001), number of relapses (P = 0.001), and early relapse (P = 0.013)in acute promyelocytic leukemia patients. PMID: 26294332
- Data show that the tumor suppressor RASSF1A is a direct target of the PML/RARalpha-regulated microRNAs miR-181a/b cluster. PMID: 26041820
- These results suggest that overexpression of RARA enhances malignant transformation during mammary tumorigenesis. PMID: 25300573
- E2F1 is found to downregulate retinoic acid receptor alpha (RARalpha), a key factor determines the effectiveness of all-trans retinoic acid. PMID: 24608861
- bortezomib impairs the UPS that controls normal protein homeostasis by causing excessive accumulation of PML-RARA augmenting ER stress and leading to acute promyelocytic leukemia cell death PMID: 26026090
- CDKN2D repression by PML/RARalpha disrupts both cell proliferation and differentiation in the pathogenesis of acute promyelocytic leukemia. PMID: 25275592
- These results indicate that NPM-RAR, not RAR-NPM, is the prime mediator of myeloid differentiation arrest in t(5;17) APL. PMID: 23927396
- This study identifies a novel mechanism through which NPM-RAR affects leukemogenesis PMID: 25033841
- Data indicate that retinoic acid receptor (RAR) is crucial for regulating sodium taurocholate cotransporting polypeptide (NTCP) expression that determines permissiveness to hepatitis B virus (HBV) infection. PMID: 25550158
- Human miR-138 promotes tau phosphorylation by directly targeting the RARA and the associated GSK-3beta pathway. PMID: 25680531
- Down-regulation of NLS-RARalpha expression inhibited the proliferation and induced the differentiation of HL-60 cells. On the contrary, over-expression of NLS-RARa promoted proliferation and reduced the ATRA-induced differentiation of HL-60 cells. PMID: 24516348
- PML-RARalpha cooperates with HIF-1alpha to activate a pro-leukemogenic program. PMID: 24711541
- Results show that UTX interacts with the retinoic acid receptor alpha (RARalpha) and this interaction is essential for proper differentiation of leukemic U937 cells in response to retinoic acid. PMID: 25071154
- SUMO-1 modification of RARA is a potent mechanism for balancing proliferation and differentiation by controlling the stability of RARA in cancer cells. PMID: 24819975
- The current status of knowledge indicates that there might be inter- or overlapping actions between PPARg and RARs, and there might be an association of PPARg/RARs(RARa, RARb, and RARg) with renal diseases PMID: 24050824
- PML/RARalpha suppresses PU.1-dependent activation of the proteasome immunosubunits in acute promyelocytic leukemia. PMID: 23770850
- The presence of a mutation in the arsenic-binding domain of PML-RARA led to arsenic resistance in patients with acute promyelocytic leukemia. PMID: 24806185
- The objective was to describe the frequency of molecular subtypes of PML/RARalpha in patients with acute promyelocytic leukemia (APL) and their distribution according to risk of recurrence and cytomorphology PMID: 23612809
- provide evidence for the existence of a functional ternary complex containing TDG, CBP and activated RARalpha PMID: 24394593
- Differences in RAR and RXR subtype mRNA expression patterns in various PTCs may contribute to the immunochemistry data available, and may thus find exploitation in clinical oncology, particularly in the differential diagnosis of thyroid neoplasms. PMID: 23969901
- The tumor suppressor gene DAPK2 is induced by the myeloid transcription factors PU.1 and C/EBPalpha during granulocytic differentiation but repressed by PML-RARalpha in APL. PMID: 24038216
顯示更多
收起更多
-
相關疾病:Chromosomal aberrations involving RARA are commonly found in acute promyelocytic leukemia. Translocation t(11;17)(q32;q21) with ZBTB16/PLZF; translocation t(15;17)(q21;q21) with PML; translocation t(5;17)(q32;q11) with NPM. The PML-RARA oncoprotein requires both the PML ring structure and coiled-coil domain for both interaction with UBE2I, nuclear microspeckle location and sumoylation. In addition, the coiled-coil domain functions in blocking RA-mediated transactivation and cell differentiation.
-
亞細胞定位:Nucleus. Cytoplasm.
-
蛋白家族:Nuclear hormone receptor family, NR1 subfamily
-
組織特異性:Expressed in monocytes.
-
數據庫鏈接:
Most popular with customers
-
-
YWHAB Recombinant Monoclonal Antibody
Applications: ELISA, WB, IHC, IF, FC
Species Reactivity: Human, Mouse, Rat
-
Phospho-YAP1 (S127) Recombinant Monoclonal Antibody
Applications: ELISA, WB, IHC
Species Reactivity: Human
-
-
-
-
-